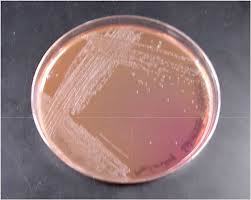
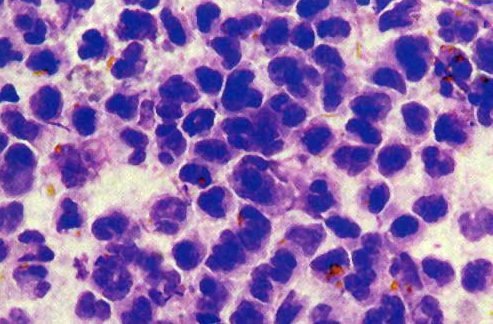
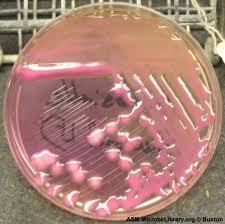
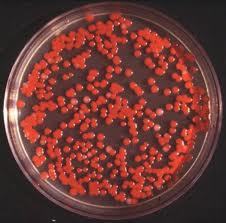

What would you expect to see on gram stain of the organism cultured from the finding here?

Gram - coccobacilli
(Intra-abdominal abscess = bacteroides fragilis)
List 4 virulence factors of this organism.

Organism in 2nd and 3rd tube?

2nd = Salmonella (produces H2S = black butt)
3rd = Shigella (ferments glucose only = yellow butt + red slant)
What two species could be represented on this MacConkey agar?
Shigella or Salmonella (lac -)
How do you get this infection?

Prior antibiotic use
(Note the pseudomembrane over the colonic mucosa)
In which patients would this complication occur?

Immunocompromised and chronic liver disease patients
(Bullae = V. vulnificus)
Histology of tissue infected with this microbe would reveal ____. What symptoms would the patient exhibit?

Cytoplasmic inclusion bodies (viroplasms where assembly occurs)
Young child/infant with diarrhea
(Two outer shells + double-stranded RNA = rotavirus)
How would the infection represented below present?

Persistent diarrhea in a young kid with no inflammation or fever
(Aggregation of bacteria = EAEC)
How would the patient from whom this sample was collected present?

Fever, appendicitis-like abdominal pain, watery diarrhea followed by dysentery
(Gull-winged appearance = C. jejuni)
This finding on a fecal smear is indicative of:
Shigella
(Lots of leukocytes due to propulsion from M cells into epithelial cells = shallow ulcers)
This schematic represents which infection?

Typhoid fever
Who is most likely to become ill due to this organism?
Immunocompromised patients
(Currant jelly = Klebsiella; opportunistic pathogen)
What virulence factor causes this finding?

Shiga-like toxin (Stx) of EHEC
(Causes inhibition of protein synthesis, thus cell death, of enterocytes)
The pathogenesis of which microbe is shown below?

ETEC
(LT - activates AC; ST - activates CFTR)
A patient presents with high fever and confusion. His vitals are 102, 100/60, 50, 22. You notice the below finding on physical exam as well as splenomegaly. CBC reveals WBC 2.0 with PMNs 20%. Dx?

Typhoid fever
(Rose spots; neutropenia + splenomegaly + bradycardia = S. typhi)
Which enteric organisms can cause the findings below?

Shigella, Salmonella, Yersinia, Campylobacter
(Reiter’s syndrome = polyarthritis in large joints, urethritis, conjunctivitis))
This type of infection is particularly common in which susceptible group?

Sickle cell anemia kids
(Salmonella osteomyelitis)
Which results are consistent with inflammatory diarrhea?

Lactoferrin and calprotectin + samples
(Both indicators of WBCs in stool)
What other manifestation common to the causative agent of this finding may be present?

Conjunctivits
(Enanthema = vesicles on oral mucosa = coxsackie A; coxsackie and echoviruses can cause conjunctivitis)

This is the most common cause of:

Hemorrhagic colitis
(Stx = shiga-like toxin = EHEC)
Ddx?

Bacteroides fragilis (intra-abd abscess, PID, or pulmonary infection)
Prevotella melaninogencia (pulmonary or periodontal abscess)
A patient presents with sudden onset of joint pain in both knees. His eyes are red and swollen, about which he says he must have picked up “pink eye” from his son. He also admits a couple week history of watery diarrhea, fever, and abdominal pain radiating to the back. CT reveals the below finding, indicated by the arrow. Diagnosis?

Yersinia enterocolitica with Reiter’s syndrome
(Mesenteric lymphadenitis shown in CT + appendicitis-like pain = Yersinia; arthritis + conjunctivitis + urethritis = Reiter’s syndrome, a complication of Salmonella, Shigella, Yersinia, and Campylobacter)
This organism was cultured from a hospitalized patient with a UTI. Dx?
Serratia
(Brick-red colonies)
What is denoted by the star?

Attachment-Effacement lesion of EHEC/EPEC
(LEE gene product causes rearrangement of actin to create pedestal that aids in EHEC/EPEC attachment)